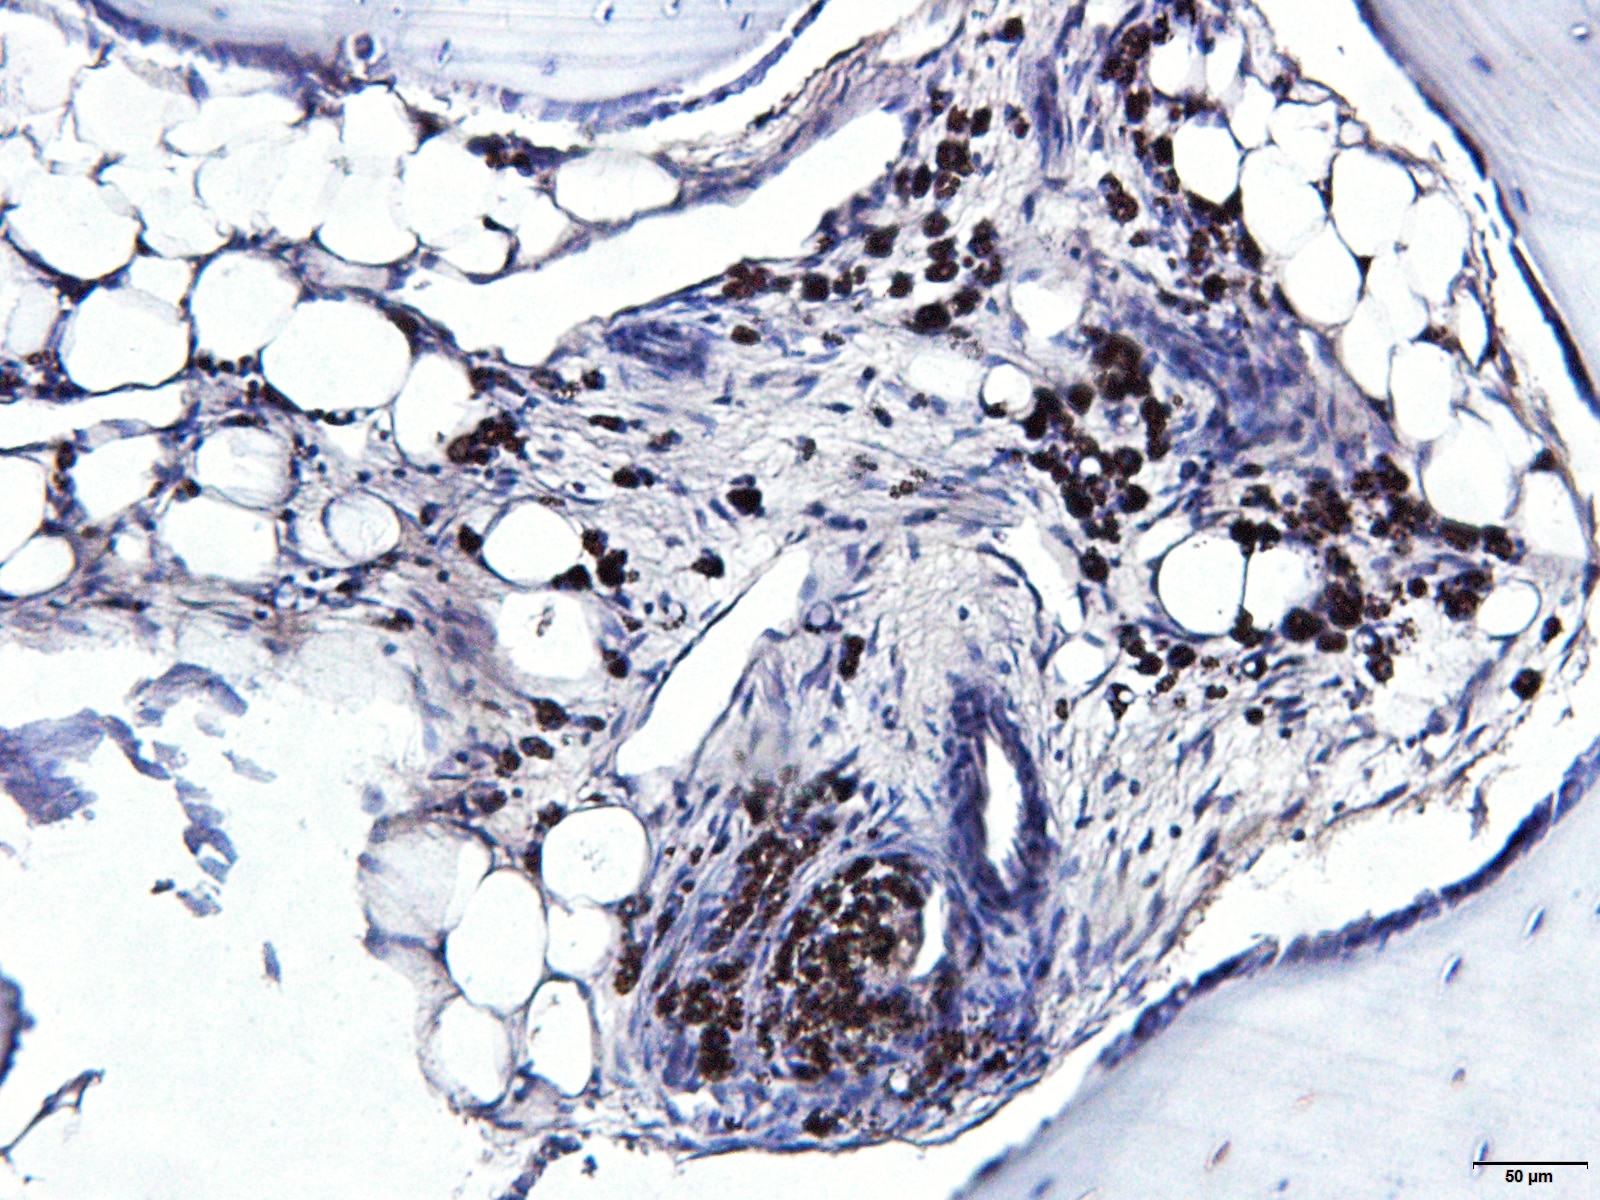

| Reactivity | Hu, Mu, Ch, Eq, Gt, Pm, Rt, CaSpecies Glossary |
| Applications | WB, IHC |
| Clonality | Polyclonal |
| Host | Rabbit |
| Conjugate | Unconjugated |
| Format | BSA Free |
| Concentration | 1.0 mg/ml |
| Description | Novus Biologicals Rabbit RUNX2/CBFA1 Antibody - BSA Free (NBP2-24755) is a polyclonal antibody validated for use in IHC and WB. Anti-RUNX2/CBFA1 Antibody: Cited in 5 publications. All Novus Biologicals antibodies are covered by our 100% guarantee. |
| Immunogen | This RUNX2/CBFA1 Antibody was developed against a synthetic peptide corresponding to somewhere between amino acids 250-300 of human RUNX2 was used as immunogen for RUNX2/CBFA1 Antibody. RUNX2 and RUNX1 share an approximate 66% homology in peptide sequence used as immunogen. |
| Predicted Species | Rat (90%), Canine (90%). Backed by our 100% Guarantee. |
| Isotype | IgG |
| Clonality | Polyclonal |
| Host | Rabbit |
| Gene | RUNX2 |
| Purity | Protein G purified |
| Innovator's Reward | Test in a species/application not listed above to receive a full credit towards a future purchase. |
| Dilutions |
|
|
| Theoretical MW | 56.6 kDa. Disclaimer note: The observed molecular weight of the protein may vary from the listed predicted molecular weight due to post translational modifications, post translation cleavages, relative charges, and other experimental factors. |
|
| Reviewed Applications |
|
|
| Publications |
|
| Storage | Store at -20C. Avoid freeze-thaw cycles. |
| Buffer | PBS |
| Preservative | 0.05% Sodium Azide |
| Concentration | 1.0 mg/ml |
| Purity | Protein G purified |

| Images | Ratings | Applications | Species | Date | Details | ||||||||||
|---|---|---|---|---|---|---|---|---|---|---|---|---|---|---|---|
Enlarge |
reviewed by:
Verified Customer |
IHC-P | Goat | 07/29/2025 |
Summary
Comments
|
||||||||||

Enlarge |
reviewed by:
Verified Customer |
WB | Goat | 05/13/2025 |
Summary
Comments
|
Secondary Antibodies |
Isotype Controls |
Research Areas for RUNX2/CBFA1 Antibody (NBP2-24755)Find related products by research area.
|
The concentration calculator allows you to quickly calculate the volume, mass or concentration of your vial. Simply enter your mass, volume, or concentration values for your reagent and the calculator will determine the rest.
5 | |
4 | |
3 | |
2 | |
1 |
| Verified Customer 07/29/2025 |
||
| Application: | IHC-P | |
| Species: | Goat |
| Verified Customer 05/13/2025 |
||
| Application: | WB | |
| Species: | Goat |